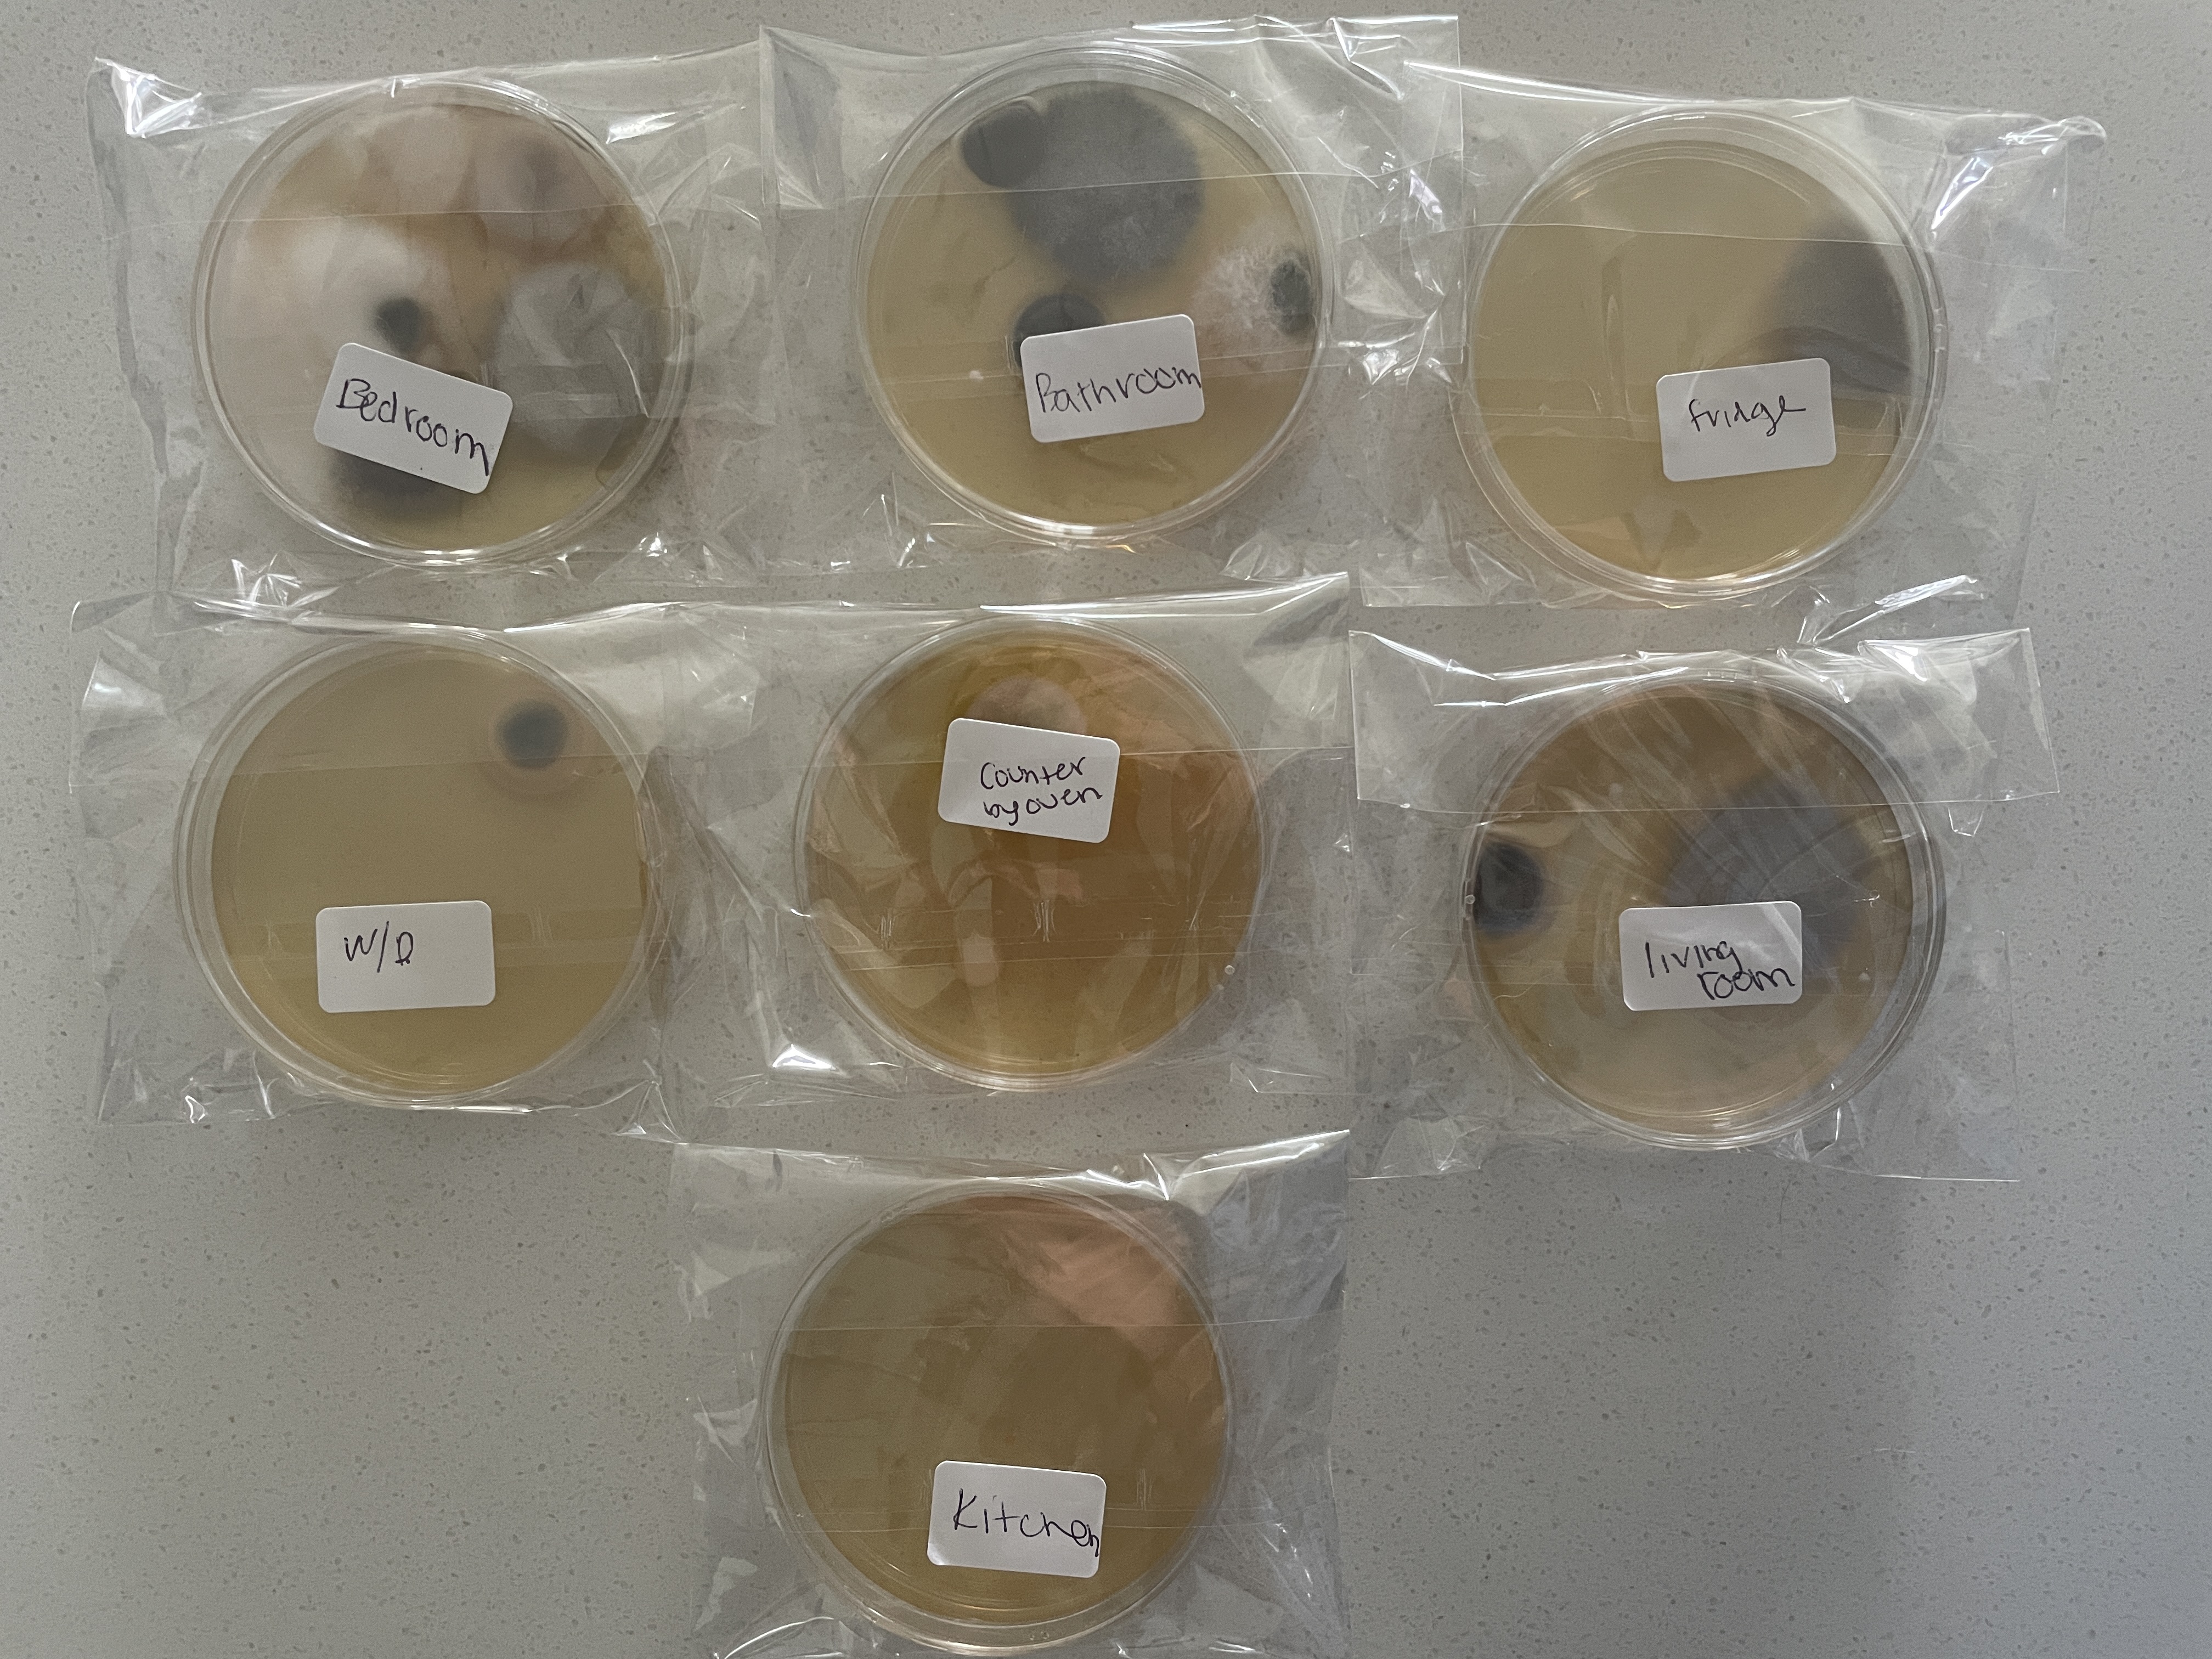

This profile has not been claimed by the business owner or representative.
to update business information, get appointment requests, engage visitors with web chat, and more!
3100 NE 190th St, Aventura, FL, 33180, United States
Get directions| Weekday | Schedule | Status |
|---|---|---|
| Mon | 9:00 a.m. to 6:00 p.m. | |
| Tue | 9:00 a.m. to 6:00 p.m. | |
| Wed | 9:00 a.m. to 6:00 p.m. | |
| Thu | 9:00 a.m. to 6:00 p.m. | |
| Fri | 9:00 a.m. to 6:00 p.m. | |
| Sat | 10:00 a.m. to 5:00 p.m. | |
| Sun | Closed |
I’ve been a resident here for six months, and I honestly cannot wait for my lease to end. The only redeeming thing about this complex is the concierge and maintenance staff — they’re professional and helpful, even though management clearly isn’t. I recently had an air quality test done in my apartment, and the results showed elevated mold levels. The test was done out of my own pocket because per the leasing office, "if I wish to conduct a mold test, I need to do so at my own expense." I immediately notified the leasing of... read more
I’ve lived in several Camden properties, and I can confidently say I’ll never live in one again, for many reasons. As a tenant, you’re expected to pay for amenities even when they don’t work. My Wi-Fi and cable service were constantly unreliable, going out every other day. I had technicians come out multiple times, but the issue was never resolved. Despite this, I was still charged full price every month, and the office management never stepped in to help. The trash situation was another ongoing issue. Dumpsters were freque... read more
Not safe here. Had my truck's Window broken and an inside item stolen on September 10th. The truck camera shows the individual driving by and breaking the window at 5:48 a.m. Police report attached. The Camden Brushy Creek office reported that its camera does not display the vehicle's license plate. Not safe here.




I truly wish I read these reviews prior to moving in this complex. My son transferred apartments and I moved with him. The charges after moving out are absolutely a scam. They have pretend bathtub glazing charges of $600. I have never been charged this anywhere before. The tubs peel every time you use them. We were placed in a "newly remodeled" unit with an unattached garage. The garage is disgustingly filthy, holes in the ceiling with a horrific and extremely loud screeching noise. We were given a key to the garage as well ... read more
CAMDEN LAS OLAS SUCKS BALLS! DO NOT MOVE HERE! I moved in March 2025. It is the end of March 2025 at the time of writing this review. So why does the Camden Las Olas suck a huge BBC? Make sure to read the 8th comment, if you're not going to read everything. It could save you some money. 1. The pool has never been functional since I moved in 3 months ago. 2. The inconvenient gym: With the pool closed, getting to the gym is a whole ordeal. First, you have to take the building’s elevator (if it’s even working, more on that lat... read more
If I could give this place negative stars I would, DO NOT EVER LIVE HERE. The staff was awful and unhelpful and didnt ever support us. My roommate has his truck stolen, out of the "gated" garage, 1 out of the 6 that were stolen in under one year, there were gnats, cockroaches, feces and urine all throughout the property and management took weeks to address these issues. I had multiple packages stolen as well and got no support from any staff at the property. I never felt safe or sanitary at any point living here and I would ... read more
Came from out of town to visit my cousin on 8/18/24 got there at 11:00 a.m they had my car towed because I didn't have a decal on it and wasn't in a visitor parking keep in mind the visitor parking space is not visible mark that's a bunch of bullshit them and the towing company is complete scammers it cost 265.00 to get my car back smdh 0 stars don't recommend this shit hole to anyone!!!!!
Run from this place. Absolutely awful. Rude manager, high crime, ZERO enforcement of rules, hundreds of SCREAMING children, awful smells. This complex is literally a refugee camp. Numerous hidden fees. If you dream of living in a 3rd world slum, behind an Indian restaurant that is being closed by the health department, with neighbors who congregate in breezeways you will love it here. To say it's awful is an understatement. JUST RUN
Management is horrible. Pest infestation, tenants are assaulted by trespassers. Packages stolen often. Maintenance takes weeks. Cars stolen and set on fire…. Told management about our rodent issue. They said that they took care of the holes left in our walls (by maintenance replacing appliances). Moved out and found droppings all in our clothes… which led us to believe nothing was taken care of. They assured us that there werent any rodents in there because traps were empty… but didnt notify us that the building was infested... read more
Camden Aventura Apartments has a 4.2 star rating with 508 reviews.
Camden Aventura Apartments is closed now. It will open tomorrow at 9:00 a.m.
Speak with a specialist to learn how you can grow with Birdeye. We are reachable at profiles@birdeye.com